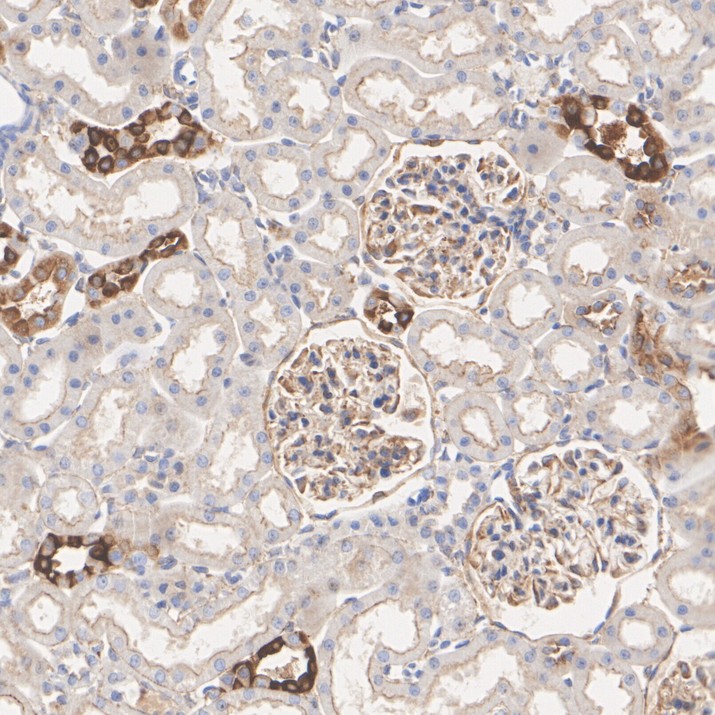
HA751579_5.jpg

non-muscle Myosin IIB / MYH10 Recombinant Rabbit Monoclonal Antibody [PSH15-72]

cat.: HA751579
| Product Type: | Recombinant Rabbit monoclonal IgG, primary antibodies |
|---|---|
| Species reactivity: | Human, Mouse, Rat |
| Applications: | WB, IHC-P, IF-Cell, FC |
| Clonality: | Monoclonal |
| Clone number: | PSH15-72 |
| Form: | Liquid |
| Storage condition: | Store at +4℃ after thawing. Aliquot store at -20℃. Avoid repeated freeze / thaw cycles. |
| Storage buffer: | 1*PBS (pH7.4). |
| Concentration: | 1ug/ul |
| Purification: | Protein A affinity purified. |
| Molecular weight: | Predicted band size: 229 kDa |
| Isotype: | IgG |
| Positive control: | 293T cell lysate, HeLa cell lysate, A549 cell lysate, Hepa1-6 cell lysate, Rat liver tissue lysate, HeLa, human kidney tissue, mouse kidney tissue, rat kidney tissue, 293T. |
| Subcellular location: | Cell projection, lamellipodium; Cell membrane. |
| Recommended Dilutions:
WB IHC-P IF-Cell FC |
1:2,000 1:3,000 1:1,000 1:1,000 |
| Uniprot #: | SwissProt: P35580 Human | Q61879 Mouse | Q9JLT0 Rat |
| Alternative names: | Cellular myosin heavy chain Cellular myosin heavy chain type B Cellular myosin heavy chain type B type B MGC134913 MGC134914 MYH 10 Myh10 MYH10_HUMAN Myosin 10 Myosin heavy chain 10 Myosin heavy chain 10 non muscle Myosin heavy chain Myosin heavy chain non muscle 11b Myosin heavy chain nonmuscle IIb Myosin heavy chain nonmuscle type B Myosin heavy polypeptide 10 non muscle Myosin-10 Myosin10 NMMHC B NMMHC II b NMMHC II-b NMMHC IIB NMMHC-B NMMHC-IIB NMMHCB Non muscle myosin heavy chain B Non muscle myosin heavy chain IIB Non muscle myosin II heavy chain B non-muscle IIb Non-muscle myosin heavy chain B Non-muscle myosin heavy chain IIb Nonmuscle myosin heavy chain B Nonmuscle myosin heavy chain IIB Nonmuscle myosin II heavy chain B Nonmuscle myosin IIB type B |
Images

|
Fig1:
Western blot analysis of non-muscle Myosin IIB / MYH10 on different lysates with Rabbit anti-non-muscle Myosin IIB / MYH10 antibody (HA751579) at 1/2,000 dilution. Lane 1: 293T cell lysate Lane 2: HeLa cell lysate Lane 3: A549 cell lysate Lane 4: Hepa1-6 cell lysate Lane 5: Rat liver tissue lysate Lysates/proteins at 20 µg/Lane. Predicted band size: 229 kDa Observed band size: 229 kDa Exposure time: 51 seconds; ECL: K1801; 4-20% SDS-PAGE gel. Proteins were transferred to a PVDF membrane and blocked with 5% NFDM/TBST for 1 hour at room temperature. The primary antibody (HA751579) at 1/2,000 dilution was used in primary antibody dilution (K1803) at 4℃ overnight. Goat Anti-Rabbit IgG - HRP Secondary Antibody (HA1001) at 1/50,000 dilution was used for 1 hour at room temperature. |

|
Fig2:
Immunocytochemistry analysis of HeLa cells labeling non-muscle Myosin IIB / MYH10 with Rabbit anti-non-muscle Myosin IIB / MYH10 antibody (HA751579) at 1/1,000 dilution. Cells were fixed in 4% paraformaldehyde for 15 minutes at room temperature, permeabilized with 0.1% Triton X-100 in PBS for 15 minutes at room temperature, then blocked with 1% BSA in 10% negative goat serum for 1 hour at room temperature. Cells were then incubated with Rabbit anti-non-muscle Myosin IIB / MYH10 antibody (HA751579) at 1/1,000 dilution in 1% BSA in PBST overnight at 4 ℃. Goat Anti-Rabbit IgG H&L (iFluor™ 488, HA1121) was used as the secondary antibody at 1/1,000 dilution. PBS instead of the primary antibody was used as the secondary antibody only control. Nuclear DNA was labelled in blue with DAPI. Beta tubulin (HA601187, red) was stained at 1/100 dilution overnight at +4℃. Goat Anti-Mouse IgG H&L (iFluor™ 594, HA1126) was used as the secondary antibody at 1/1,000 dilution. |

|
Fig3:
Immunohistochemical analysis of paraffin-embedded human kidney tissue with Rabbit anti-non-muscle Myosin IIB / MYH10 antibody (HA751579) at 1/3,000 dilution. The section was pre-treated using heat mediated antigen retrieval with Tris-EDTA buffer (pH 9.0) for 20 minutes. The tissues were blocked in 1% BSA for 20 minutes at room temperature, washed with ddH2O and PBS, and then probed with the primary antibody (HA751579) at 1/3,000 dilution for 1 hour at room temperature. The detection was performed using an HRP conjugated compact polymer system. DAB was used as the chromogen. Tissues were counterstained with hematoxylin and mounted with DPX. |

|
Fig4:
Immunohistochemical analysis of paraffin-embedded mouse kidney tissue with Rabbit anti-non-muscle Myosin IIB / MYH10 antibody (HA751579) at 1/3,000 dilution. The section was pre-treated using heat mediated antigen retrieval with Tris-EDTA buffer (pH 9.0) for 20 minutes. The tissues were blocked in 1% BSA for 20 minutes at room temperature, washed with ddH2O and PBS, and then probed with the primary antibody (HA751579) at 1/3,000 dilution for 1 hour at room temperature. The detection was performed using an HRP conjugated compact polymer system. DAB was used as the chromogen. Tissues were counterstained with hematoxylin and mounted with DPX. |
|
Fig5:
Immunohistochemical analysis of paraffin-embedded rat kidney tissue with Rabbit anti-non-muscle Myosin IIB / MYH10 antibody (HA751579) at 1/3,000 dilution. The section was pre-treated using heat mediated antigen retrieval with Tris-EDTA buffer (pH 9.0) for 20 minutes. The tissues were blocked in 1% BSA for 20 minutes at room temperature, washed with ddH2O and PBS, and then probed with the primary antibody (HA751579) at 1/3,000 dilution for 1 hour at room temperature. The detection was performed using an HRP conjugated compact polymer system. DAB was used as the chromogen. Tissues were counterstained with hematoxylin and mounted with DPX. |

|
Fig6:
Flow cytometric analysis of 293T cells labeling non-muscle Myosin IIB / MYH10. Cells were fixed and permeabilized. Then stained with the primary antibody (HA751579, 1/1,000) (red) compared with Rabbit IgG Isotype Control (green). After incubation of the primary antibody at +4℃ for an hour, the cells were stained with a iFluor™ 488 conjugate-Goat anti-Rabbit IgG Secondary antibody (HA1121) at 1/1,000 dilution for 30 minutes at +4℃. Unlabelled sample was used as a control (cells without incubation with primary antibody; black). |
Note: All products are “FOR RESEARCH USE ONLY AND ARE NOT INTENDED FOR DIAGNOSTIC OR THERAPEUTIC USE”.